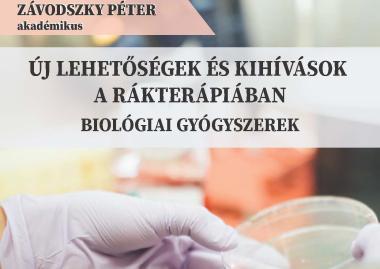
Új lehetőségek és kihívások a rákterápiában. Biológiai gyógyszerek

Elsődleges fülek
II. Természettudományi Szakosztály
A Természettudományi Szakosztály munkaterve a 2024-es évre
1. Havi ülések.
A szakosztályi havi felolvasó ülések (altalában) minden hó utolsó csütörtökén, d.u. 17 órai kezdettel az EME Napoca (Jókai) utcai 2 sz. alatti székházában lesznek megtartva, on-line internetes hozzáféréssel is.
- 2024. február 22. – Dr. Szőcs Katalin: Tél, a víz évszaka
- 2024. április 25. – Dr. Buta Erzsébet: Biokertek
- 2024. május 30. – Dr. Tóthfalussy-Veress Éva: A Kolozsvári Magyar Királyi Ferenc József Tudományegyetem Állattani tanszékének története (1872-1919)
- 2024. június 27. – Dr. Sándor Bulcsú: A fizika és a robotika határán: robotok mozgása önszerveződő módon
- 2024. szeptember 26. – Dr. Uray Zoltán: Az emberi élettartam meghosszabbításának lehetőségei biológus szemmel
- 2024. október 24. – Székely Sebestyén György: Természettudomány és szépművészet
2. Részvétel a Kolozsvári Magyar Napokon (2024. augusztus)
Mottó: “Egészség és jólét”
Műhely 1: augusztus 19 (10:30 óra), EME székház
- Dr. Tóthfalussy-Veress Éva: ” Kertek…”.
- Dr. Szőcs Katalin: ” A nyár…”.
Műhely 2: augusztus 20. (17 óra), EME székház
- Dr. Páll Emőke, Az ember-állat interakciók egészségügyi előnyei
- Dr. Virág Piroska, Nagyvárosi kiskert projekt: a hobbitól az egészséges életmódig
Műhely 3: augusztus 21 (10:30 óra), EME székház
- Dr. Kékedy-Nagy László: ” Kék aranyunk, a víz. ”
- Dr. László Zoltán: “Levegő… “
3. MTNE Erdélyi Természettudományi Konferencia is megszervezésre kerül november 23-án. Egy meghívott plenáris előadás után (“Mértékegységek és mérőrendszerek: múlt, jelen és jövő”) a résztvevők több tudományos szekcióba lesznek beosztva, így a bemutatásra kerülő kutatási eredmények, a természettudományok különböző területeit fogják ismertetni. Minden szekció keretén belül továbbra is egy-egy egyetemi hallgató, illetve egy-egy doktorandusz / fiatal kutató munkája lesz kitüntetve és díjazva. A díjak, az EME és a szakosztály által kiállított diplomákon kívül, a támogatók segítségével összeállított ajándékcsomagból állnak majd.
-----------------------------
A Természettudományi Szakosztály munkaterve a 2023-as évre
1. Havi ülések.
A szakosztályi havi felolvasó ülések (altalában) minden hó utolsó csütörtökén, d.u. 17 órai kezdettel az EME Napoca (Jókai) utcai 2 sz. alatti székházában lesznek megtartva, on-line internetes hozzáféréssel is.
2023. január 26. Szakosztályi évi közgyűlés
2023. február 23. Dr. Szacsvai Kinga: Négy fal között a radonnal és egyebekke, a beltéri levegőminőség fontossága napjainkban
2023. március 30. Mihály-Demeter Sarolta Katinka: Egységes természettudományi oktatás. A „Cambridge" model
2023. április 20 Dr. Szőcs Katalin A tavaszi erők hatása
2023. május 25. Orban-Bakk Kincső: Egyéni és szociális immunitás a társas rendszerekben
2023. július 13.Dr. Tóthfalussy-Veress Éva: Adalékok a Ferenc József Tudományegyetem Növénytani Intézetének működéséhez
2023. szeptember 28. Dr. Guttmann Márta: Természettudományos módszerek és vizsgálatok a műtárgyvédelemben és műtárgyvizsgálatban
2023. október 26.Dr. Buta Erzsébet: Biokertek
2. Egyéb tudományos tevékenységek és események.
2023. május 11-13 Oktatói műhely:„1. Erdélyi Természettudományi Oktatói Fórum" (1. ETOF)(a BBTE támagotásával és VI. EME Szakosztályal közreműködésével) -
2023. augusztus 15-17: 14. Kolozsvári Magyar Napok
Kerekasztal: „Egészségünk"
1. Dr. Virág Piroska: A daganatok mikrókörnyezete: lehetséges célpontok a rákos daganatok kezelésében
2. Dr. Rácz Csaba: Növények az egészségünk szolgálatában (Ideiglenes cím)
3. Dr. Szacsvai Kinga: Beltéri levegőminőség
2023. november 18. 22. Magyar Tudomány Napja Erdélyben
„22. Erdélyi Természettudományi Konferencia" (22. ETK)
„1. Ifjú kutatók fóruma" (1. IKF) - egyetemi hallgatók számára (*Tervben)
*A Természettudományi Szakosztály vezetősége a változás jogát fenntartja.